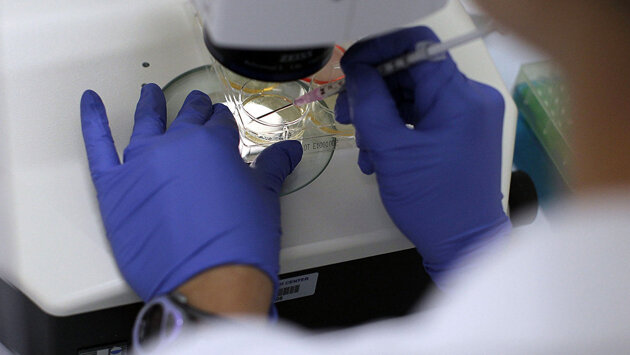

Nature (Великобритания): мощный эффект японской политики по стволовым клеткам
Двумя этажами выше дорогой французской кондитерской, по соседству с маникюрными салонами и ювелирными мастерскими, в самом модном районе Токио спряталась клиника «Элен» (Helene). Там лечат сердечно-сосудистые заболевания инъекциями стволовых клеток. Модно одетые администраторши с большими бантами на воротниках встречают медицинских туристов из Китая и провожают их мимо аквариума в смотровые комнаты. Лечение как правило начинается с того, что врачи берут биопсию кожи за ухом и извлекают стволовые клетки из жировой ткани. Затем клетки размножают и вводят их внутривенно. Утверждается, что они сами чинят поврежденные области — в данном случае, артерии, затвердевшие от атеросклероза. Плакаты на стене сулят многообещающие результаты, им вторят крупные фармацевтические компании и публикации в ведущих научных журналах. Они придают солидности, пусть о лечении, которое предлагает клиника, ни в одном из этих журналов нет ни слова о том, какими же средствами достигаются результат. Когда один посетитель (не представившись журналистом) потребовал подробностей, администраторша призналась, что доказательствами эффективности конкретно этого лечения она не располагает, сославшись на то, что все индивидуально. Как она объяснила, эти процедуры делаются больше для профилактики. «Это для предотвращения старения», — объяснила она. В гонке за стволовыми клетками нет победителя Когда корреспондент «Нейчер» позднее связался с компанией, вооружившись целым списком вопросов, ее представитель отказался приводить как свидетельства эффективности лечения, так и элементарную информацию о количестве пациентов, отметив, что эти сведения вскоре будут обнародованы на презентации. При этом он заверил, что клиника «Элен» прошла все необходимые проверки, что ее процедуры одобрены законом и что ни один пациент не жаловался на побочные эффекты. Клиники вроде этой предлагают непроверенные методы лечения стволовыми клетками. Это не новость, и одной Японией дело не ограничивается. Их расплодилось огромное количество во всему миру — от Мексики до Украины, Индии и Австралии, и надзорные органы едва за ними поспевают. В США власти столкнулись с настоящим наплывом клиник, которые предлагают никем не одобренные препараты, от которых пациентам больше вреда, чем пользы. В Японии, однако, дело приобрело и вовсе опасный оборот: стволовые клетки не только не запрещены, но и всячески продвигаются в высших эшелонах власти. А причиной тому пара законов, призванных стимулировать бизнес и вывести Японию в лидеры регенеративной медицины. Законы вступили в силу пять лет назад, и теперь сотни клиник по всей стране предлагают более 3 700 видов процедур на основе стволовых клеток. Свои филиалы открывают и иностранные компании. «Япония стала центром развития инновационных методов лечения», — говорит Гил ван Боккелен (Gil Van Bokkelen), исполнительный директор биотехнологической компании «Этерсис» (Athersys) из Кливленда, штат Огайо. Она проводит клинические испытания японского метода лечения инсульта и респираторных заболеваний стволовыми клетками. При этом многие компании ищут лазейку в законе, чтобы поскорее вывести свои методы и препараты на рынок в обход тщательного тестирования. Ученые подозревают, что пациенты в таком случае шансов вылечиться лишаются. Даже методы лечения серьезных заболеваний получают сертификат, несмотря на скудность доказательств. Между тем, уже зарегистрировано четыре случая серьезных побочных эффектов, а также одна смерть. Даже ученые из государственных институтов и сторонники существующего законодательства признают, что назрела необходимость перемен в законах. Клиники говорят, что полностью соблюдают закон. А чиновники утверждают, что японская система все равно надежнее других, потому что результаты пристальным образом отслеживаются. Но такой подход может внушить людям ложную надежду на выздоровление. Между тем у смелого эксперимента по либерализации рынка нашлись последователи. Японскому примеру уже последовали Тайвань и Индия. На власти по всему миру все сильнее давят компании, пациенты и поборники регенеративной медицины с требованием облегчить и ускорить порядок сертификации. «Если по всему миру возникнут разные нормы и стандарты, вот это будет действительно большая проблема», — считает Питер Маркс (Peter Marks), директор Центра биологической оценки и исследований при Управлении по санитарному надзору за качеством пищевых продуктов и медикаментов США. Кардиолог Ёсики Юи из Киотского университета, непримиримый противник японской системы, считает, что законодательство, пусть оно и придало стимул бизнесу, было шагом недальновидным. «Никто не подумал, что будет, если что-то пойдет не так», — хмурится Юи. Безопасность, но не эффективность Едва вступив в должность в декабре 2012 года, премьер-министр Японии Синдзо Абэ пообещал в течение следующего десятилетия инвестировать в регенеративную медицину 110 миллиардов йен (1 миллиард долларов). За несколько месяцев до этого решительного шага Синъя Яманака из Киотского университета получил Нобелевскую премию по физиологии и медицине за индуцированные плюрипотентные стволовые клетки. Абэ хвастался, что Япония вышла в мировые лидеры в области регенеративной медицины, но посетовал на медленные темпы клинических испытаний. В надежде переломить ситуацию вскоре он объявил о двух мерах. Первая из них, Закон о безопасности регенеративной медицины (ASRM), был принят в ноябре 2014 года. Он разрешил больницам и клиникам лечить пациентов клеточной терапией, которая не прошла стандартные испытания. Достаточно лишь, чтобы больничный центр обработки клеток получил сертификат министерства здравоохранения. Кроме того, методика лечения должна быть одобрена независимым комитетом, тоже сертифицированным. Регистрация клиники — не гарантия Раньше не редкость были мошеннические клиники, где попросту надували медицинских туристов. Новый закон требует всеобщей регистрации, чтобы избежать каких бы то ни было сюрпризов, объясняет офтальмолог Масаё Такахаси, видный член Японского общества регенеративной медицины и участник консультативного совета при правительстве. «Замысел такой, чтобы сперва включить всех вообще, а потом постепенно вычеркивать тех, кто этого не заслуживает», — говорит она. Критики считают, что польза такого реестра обманчива. Однако Дуг Сипп (Doug Sipp), знаток регуляторной политики при Институте физико-химических исследований в Кобэ, говорит, что ясности стало больше: даже откровенным жуликам пришлось подтянуться до базового уровня. Но есть риск, что в глазах пациентов реестр станет «неким знаком качества», отмечает он. Например, фешенебельная токийская клиника «Авеню» (Avenue) больше смахивает на спа, чем на медицинский центр. О том, что ее методы лечения занесены в реестр, сообщается сразу же, на самом видном месте. По меньшей мере десять ее пациентов получили инъекции жировых стволовых клеток для лечения прогрессирующего нейродегеративного расстройства, бокового амиотрофического склероза (БАС). Представитель «Авеню» в ответ на расспросы по телефону сообщил, что после терапии стоимостью 1,5 миллиона йен за сеанс состояние 50-70% пациентов улучшилось. При благоприятном исходе рекомендуются повторные инъекции каждые два-три месяца. «Некоторые могут себе это позволить», — сообщил представитель. Всего же клиника принимает порядка тысячи пациентов в год. Доказательств эффективности просто нет Пятеро ученых, занимающихся лечением БАС при помощи регенеративной медицины, признались, что убедительных доказательств эффективности стволовых клеток нет. Более того, сообщили они, есть несколько причин думать, что они в принципе не работают. Роберт Бало (Robert Baloh) из Института регенеративной медицины Сидар-Синай в Лос-Анджелесе, штат Калифорния заявил без обиняков: «Шарлатанство впаривается пациентам сотни лет, и это ничуть не отличается». Клиника «Авеню» официальный запрос на интервью от журнала «Нейчер» отклонила, однако в электронном письме отметила, что ее методики внесены в реестр. Когда мы сослались на мнение ученых о лечении БАС, нам сообщили, что медицинский персонал клиники занят процедурами и в настоящий момент недоступен. Помимо собственно эффективности методов существуют опасения по поводу квалификации и независимости комитетов, которые одобряют процедуры перед включением в реестр. Министерство здравоохранения требует, чтобы эти комитеты насчитывали по пять-восьмь специалистов, в том числе по клеточной биологии, регенеративной медицине, клиническим исследованиям и клеточным культурам. Также требуется участие юристов, специалистов по биологической этике и статистиков. Проблема конфликта интересов, считай, не регулируется. Например, у клиники «Элен» был собственный комитет, который благополучно одобрил некоторые из ее методик, в том числе лечение атеросклероза. Представитель компании говорит, что пациентам эта терапия никогда не назначалась, а сейчас клиника обращается уже к независимому стороннему комитету. Министерство здравоохранения говорит, что внутренний комитет был распущен в марте. В «Авеню» лечение БОС и другие процедуры одобрил комитет, куда входит штатный врач. На наши вопросы клиника не ответила. В апреле министерство позаботилось о том, чтобы подобные конфликты прекратились. Но клиники добиваются разрешения даже у полностью независимых комитетов. Ёдзи Сато, глава отделения клеточной терапии Японского национального института медицинских наук в Кавасаки и сам участник двух комитетов, признает, что многие «скачут из комитета в комитет». «Иногда приключается конфликт интересов, иногда процедуры неэффективны, но на сегодняшний момент это все, что мы можем», — говорит Сато. Тем не менее, утверждает он, японская система превосходит американскую, где надзорные органы сбились с ног, гоняясь за мошенниками. Сато приводит в пример случай, когда двое человек лишились зрения после неутвержденного лечения стволовыми клетками во Флориде. Чтобы закрыть клинику, у властей ушло четыре года мучительного судебного разбирательства. В Японии же тех, кто работает без одобрения комитета, «просто заберут в полицию», говорит Сато. Условное одобрение Другая важная практика, которую учредила правительство Абэ в 2014 году, известна как Закон о фармацевтических и медицинских устройствах. По нему компания может получить «условное одобрение» для продажи лечения по всей стране — не ограничиваясь одной клиникой или больницей — причем расходы покроет система страхования. В этом случае фирме придется предоставить домогательства эффективности на основе кратких клинических испытаний. После этого процедуры можно назначать в течение семи лет, потому что считается, что за это время компания собирает новые данные об их эффективности. Пока что условное одобрение выдается на три вида заболеваний: это травмы спинного мозга, сердечно-сосудистые заболевания и ишемическая болезнь конечностей. Это крайнее болезненное состояние характеризуется снижением притока крови к конечностям. Но урезанные сроки клинических испытаний беспокоят научное сообщество. В отчете Международного общества по исследованию стволовых клеток за 2016 год говорится, что одобрение после кратких испытаний грозит уронить строгость оценки и «подорвать доверие к научным стандартам». Побочные эффекты Есть единичные свидетельства побочных эффектов. Один человек, попросивший не называть его имени, попробовал метод HeartSheet для лечения хронического сердечного заболевания. О нем он узнал из выпуска новостей в 2012 году. Причем это не лечение стволовыми клетками в строгом смысле слова. Из мышечных клеток, извлеченных из бедра пациента, формируется тонкий лист ткани и размещается на поврежденном сердце в ходе операции на грудной клетке. Ёсики Сава, хирург Университета Осаки и соавтор методики, заверил человека, что она отлично ему подойдет. Поначалу мужчина сомневался, потому что для лечения его болезни — она называется дилатационная кардиомиопатия — этот метод доселе почти не применялся. К тому же у него никогда не было операций на сердце. Но решил попробовать. По его словам, улучшения так и не настало. Более того, спустя девять месяцев он начал страдать одышкой, чего раньше не случалось. Еще через месяц он попал в больницу с сердечной недостаточностью. А еще через месяц приступ повторился. В итоге где-то через год ему сообщили, что требуется пересадка сердца. «Мне говорили, что мое состояние ухудшается, но виной ли тому процедура — непонятно», — говорит он. Без дополнительной информации сказать, вызвала ли сердечную недостаточность процедура HeartSheet, невозможно. В конце концов, это лишь частный случай, возможны и другие объяснения. Но неопределенность — лишь часть проблемы. В клинических испытаниях на сертификат участвовало лишь семь человек. О частоте и серьезности побочных эффектов почти ничего не известно. Жаркие споры кипят вокруг случайных тестов с контролем по плацебо. Вообще-то это общепринятый стандарт клинических исследований, но правительство в этом вопросе пошло за обществом регенеративной медицины. А там в 2012 году заявили, что при клинических тестах новых методов лечения вовсе не обязательно иметь контрольную группу, которая получают плацебо или традиционное лечение. Сава заявил, что в естественных условиях болезнь вышеупомянутого пациента лишь прогрессирует. У пяти из семи человек, которые получили HeartSheet, состояние не ухудшилось, поэтому создалось впечатление, что лечение помогло. Однако исследование примерно 3 500 человек показало, что состояние большинства людей со схожими сердечно-сосудистыми заболеваниями улучшается либо стабилизируется без радикального вмешательства. На запрос насчет комментария Сава не ответил. Плацебо поднимает нравственные вопросы Однако в отношении тестов с контролем по плацебо министерство здравоохранения Японии стоит на своем. После того, как на метод лечения травм спинного мозга, который получил название STR01 и поступил в продажу в мае, обрушилась критика, представитель министерства здравоохранения Синдзи Миямото заявил, что опыты двойным слепым методом «структурно невозможны» и что фиктивное лечение или плацебо лишь «поднимет нравственные вопросы». Специалисты по биологической этике долго обсуждали потенциальный вред фиктивного лечения при клинических испытаниях и то, насколько это справедливо по отношению к пациентам. Некоторые процедуры чересчур инвазивны, считает Джонатан Киммельман (Jonathan Kimmelman), биоэтик из Университета Макгилла в Монреале, Канада. Он консультировал правительство Японии по вопросам клинических испытаний. Но врачи, исследующие лечение травм спинного мозга стволовыми клетками, говорят, что тесты с контролем по плацебо в данном случае затруднений не вызывают. Осаму Хонмоу, нейрохирург Медицинского университета Саппоро, который предлагает лечение STR01, ранее отстаивал результативность двойные слепые тестов с контролем по плацебо, чтобы доказать эффективность лечения у людей, перенесших инсульт. В публикации 2016 года он рассчитывал, что к настоящему моменту они станут расхожей практикой. Однако на просьбу «Нейчер» разъяснить их целесообразность для лечения последствий инсульта, но не травм позвоночника он не откликнулся. Представитель министерства здравоохранения говорит, что в последнем случае фиктивная процедура неэтична, поскольку лечение должно быть проведено в течение определенного периода времени, и когда «окно» закроется, терапия окажется менее эффективной. Из этого, однако, следует, что само по себе лечение приносит пользу. Несколько видных японских ученых сообщили «Нейчер», что процедура STR01, также известная как Stemirac, для лечения травм спинного мозга не подходит и сертификата не заслуживает. «Кабинету Абэ срочно понадобился успех в науке, и не один, — объяснил один кардиолог, пожелавший остаться неизвестным. — Там действуют чересчур настырно». Администрация на запрос о комментариях не ответила. Мировые амбиции Несмотря на изъяны в системе, Япония добивается, чтобы ее регламент регенеративной медицины стал стандартом и в других странах — в частности, чтобы заручиться рынком сбыта для своих методик. Согласно пятилетнему плану, опубликованному в марте этого года отделом министерства здравоохранения по регулированию лекарственных средств, правительство финансирует информационные программы, нацеленные на «распространение японской модели регулирования продуктов регенеративной медицины, укрепление доверия к японским надзорным органам и внедрение японского регламента в других странах». Судя по всему, эти усилия уже начали приносить плоды, считает Сато. Тайвань свой закон об условном утверждении регенеративных лекарств сформулировал по японскому образцу, а Южная Корея в августе одобрила систему, аналогичную японской. Упоминалась японская система и в ходе дискуссий в Индии — после чего в стране в 2015 году было выдано первое условное одобрение на регенеративные процедуры одобрение. Уже в этом году о планах предоставить больницам полную свободу в использовании стволовых клеток в качестве лекарственного средства объявил материковый Китай. «Примеру Японии последовал целый ряд стран, пожертвовав благосостоянием пациентов ради превратного представления об экономической конкурентоспособности», — считает Сипп. Выход из ЕС — шанс для таких клиник в Британии? Некоторые рассчитывают увидеть подобную систему в Великобритании, отмечая что сейчас наилучший для этого момент — в связи с выходом страны из Европейского союза. Как заявил в феврале 2018 года в интервью «Би-би-си» Аджан Реджинальд (Ajan Reginald), соучредитель и исполнительный директор компании из Стратфорда-на-Эйвоне «Селиксир» (Celixir), которая занимается клеточной терапией «Хартсел» (Heartcel) для лечения сердечных заболеваний, Брексит — это шанс для Великобритании пойти собственным путем и существенно упростить надзорное законодательство. «Многие в Великобритании с воодушевлением заглядываются на японскую модель», — говорит Патрисия Мюррей (Patricia Murray), специалист в области биологии стволовых клеток Ливерпульского университета. По ее словам, либерализация рынка по японскому образцу позволит компаниям «впаривать свои поддельные методы лечения потребителям напрямую». Чересчур поспешное развитие уже стало головной болью для надзорных органов других стран. На Управление по санитарному надзору за качеством пищевых продуктов и медикаментов США все сильнее давят компании и потребительские организации, требуя перейти на японскую модель. С такими же требованиями выступают Калифорнийский институт регенеративной медицины и консервативный аналитический центр Хартлендский институт. Маркс предвидит трудности. Люди всегда могут сослаться на Японию и пожаловаться: «Ребята, да вы вообще ничего не одобряете». На майской конференции по медицинской журналистике в Балтиморе, штат Мэриленд, он подтвердил, что его управление добивается, чтобы новые методы лечения стали доступнее. «Мы просто хотим убедиться, что они безопасны и эффективны». Плюсы от японского давления Ли Баклер (Lee Buckler), исполнительный директор компании «Реплисел» (RepliCel) в из Ванкувера, Канада — в 2016 году она лицензировала свой продукт для омоложения кожи у токийской косметической компании «Сисэйдо» (Shiseido) — видит в этом давлении массу плюсов. Люди видят, что происходит в Японии, говорит он, и «добиваются, чтобы в их стране все было так же доступно». Гордость за японские достижения в области биологии стволовых клеток и регенеративной медицины предопределила дальнейшее развитие отрасли. Но Яманака — один из ключевых деятелей в этой области — на политику дерегуляции смотрит спокойно. Несмотря на стремительные изменения в других частях страны, институт Яманаки, который занимается практическим применением стволовых клеток, с клиническими испытаниями, кажется, не спешит. «Двойной слепой контроль следует проводить при любой возможности», — считает Яманака. И хотя он признает, что для некоторых типов клеточной терапии это может быть затруднительно, даже тогда ученые должны «сделать все возможное, чтобы добиться как можно большей объективности и научного подхода». Некоторые исследователи стволовых клеток считают, что без объективных и строго научных мер разобраться, кому доверять, а кому нет, трудно. «Это проблема», — приезнает Такахаси. «Закон придуман для хороших людей. Но есть немало плохих». Тем не менее, в будущее она смотрит с оптимизмом. «Через десять лет клеточная терапия выйдет на достойный уровень. А пока потерпим и критику».